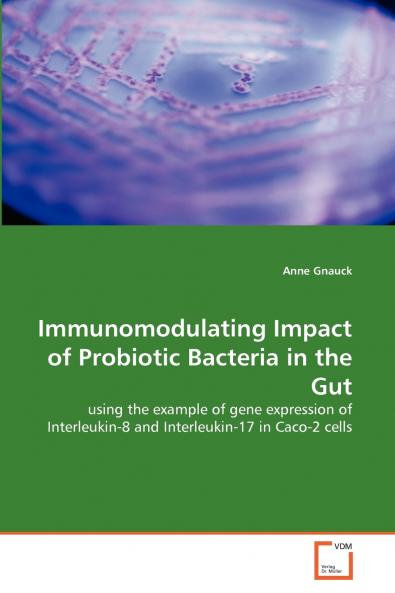
Immunomodulating Impact of Probiotic Bacteria in the Gut

English
Paperback
₹5357
(All inclusive*)
Delivery Options
Please enter pincode to check delivery time.
*COD & Shipping Charges may apply on certain items.
Review final details at checkout.
Looking to place a bulk order? SUBMIT DETAILS
About The Book
Description
Author
The gut is the largest human organ where interactions with the environment take place. A special role plays commensal gut bacteriaalso called as microbiota. The interaction among microbiota and the human immune system are crucial for the maintenance of human immune system. An imbalance of immune response leads to chronic inflammation and further to the development of some diseases. It is well known that kind of diet and special foods or nutrients have an effect on appearance and concentration of inflammatory mediators and may affect the symptoms of diseases on a beneficial as well as on a negative way. Probiotics are discussed as a functional food. The autor Anne Gnauck gives an overview about microbiota the intestinal immune system and the interaction among both in the first part. In the second part she explains her research project. The aim of the study was to investigate the influence of probiotic bacteria on inflammatory mediator IL-8 and IL-17 as well as their effect on caspase-3 mediated apoptosis. IL-8 ELISA and gene expression of IL-8 IL-17 and CASP3 were analyzed in Caco-2 cells after treatment with probiotic bacteria and commensal gut bacteria.
Delivery Options
Please enter pincode to check delivery time.
*COD & Shipping Charges may apply on certain items.
Review final details at checkout.
Details
ISBN 13
9783639362060
Publication Date
-09-06-2011
Pages
-108
Weight
-158 grams
Dimensions
-150x220x6.15 mm